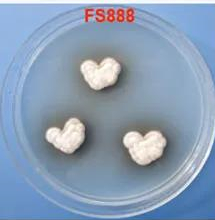

Antibacterial and NF-κB Inhibitory Lumazine Peptides, Aspoch
发布日期:2020-07-13 21:41
来源:J. Nat. Prod.
作者:Shugeng Cao
浏览次数:
Antibacterial and NF-κB Inhibitory Lumazine Peptides, Aspochalasin, γ-Butyrolactone Derivatives, and Cyclic Peptides from a Hawaiian Aspergillus flavipes
Cong Wang, Xiaohua Wu, Helong Bai, KH Ahammad Uz Zaman, Shaobin Hou, Jennifer Saito, Supakit Wongwiwatthananukit, Kyung Sik Kim, Shugeng Cao*
J. Nat. Prod., 2020, DOI: 10.1021/acs.jnatprod.0c00344
Shugeng Cao博士及其团队成员。图片来源:Cao Lab [1]
近日,他们从一株真菌中分离鉴定出一系列结构新颖、具有抗菌和抑制NF-κB活性的化合物。这株真菌(Aspergillus flavipes FS888)正是采自夏威夷最受欢迎的海滩公园——恐龙湾(Hanauma Bay)。这里水质好、水浅、浪小,分布着多样的天然珊瑚礁石和热带鱼类,不仅是游客喜欢的潜水圣地,也是科学家研究开发独特微生物资源的理想地点。他们选择在恐龙湾南缘靠近公海的位置进行采样,以尽量避开人为活动的干扰。

夏威夷恐龙湾(Hanauma Bay)。图片来源:J. Nat. Prod.
有趣的是,这株真菌仿佛也受到夏威夷浪漫气息的感染,在固体琼脂培养基上的菌落形态很像“心”形。
菌株A. flavipes FS888在固体琼脂培养基上的菌落形态(左图)。图片来源:J. Nat. Prod.
不过菌株粗提取物的抗菌活性测试结果就没那么“浪漫”了:
在20 μg/mL的浓度下,粗提取物对金黄色葡萄球菌没有显示任何抑制活性。显然,只会卖萌“比心”的真菌对于药学研究者来说没有任何意义,这株真菌难道就此凉凉了?
Shugeng Cao博士团队在粗提物中加入双硫仑(disulfiram)进行抗金葡菌测试。这么做是因为最近的研究发现,双硫仑不仅是一种治疗慢性酒精中毒的药物,还显示了窄谱的革兰氏阳性菌抑制活性,且作为抗生素佐剂可使得致病菌对抗生素更加敏感。果然,在双硫仑(20 μM)存在下,A. flavipes FS888粗提物显示了抑制金葡菌的活性。
通过抗菌活性介导的分离纯化,他们从这株真菌中共鉴定出14个化合物。
化合物1-5通过核磁一维和二维图谱分析发现含有1,3-二甲基-6-羧基-二氧四氢蝶啶和邻苯胺片段,二者通过一个氨基酸形成两个酰胺键连接起来。化合物1-5的区别主要是氨基酸和苯环上的取代基不同。化合物8比5多出一个甲基,是5的甲酯化产物。化合物1-5、8氨基酸片段的绝对构型都通过Marfey方法进行鉴定,都是L型。化合物6、9、10是细胞松弛素类结构,其平面结构通过核磁数据确定,相对构型和绝对构型则分别通过核磁NOESY和圆二色谱(ECD)确定。化合物7、11、12是一类含丁烯内酯和苯酚片段的结构,彼此区别在于丁烯内酯和邻位苯酚上的取代基不同。通过旋光值比对和参考文献查询确定其立体构型。化合物13、14经鉴定属于环肽类化合物。结构鉴定发现化合物1-7是新结构化合物,化合物8-14属于已知化合物。

化合物1-14的化学结构。图片来源:J. Nat. Prod.
他们推测了上述化合物的生物起源。
其中,化合物1和2由二氧四氢蝶啶、丙氨酸和邻氨苯甲酸通过一系列生物反应合成。化合物3、4、5和8则分别由二氧四氢蝶啶、邻氨苯甲酸和丝氨酸、谷氨酰胺、蛋氨酸通过多步生物反应合成。化合物6、9、10属于广泛存在于真菌次级代谢产物中的细胞松弛素,它们一般由亮氨酸(或苯丙氨酸)与聚酮类化合物衍生而来。化合物7、11、12是γ-内酯类化合物,一般由苯丙氨酸通过生物合成衍生而来。

化合物1-14可能的生源合成途径。图片来源:J. Nat. Prod.
他们对分离到的化合物1-14进行了金黄色葡萄球菌和大肠杆菌的抗菌活性测试。在80 μg/mL的浓度下,没有一个化合物显示出抗菌活性。然而在20 μM双硫仑存在下,化合物12-14对金葡菌有抑制作用,最小抑制浓度(MIC)为10 μg/mL。进一步测试化合物1-14对人类卵巢癌细胞A2780的抗增殖活性,没有化合物在40 μM的高浓度下具备增殖抑制活性。他们还在哺乳动物细胞模型中评估了化合物1-14对TNF-α-诱导的NF-κB抑制活性。化合物9和13的IC50值分别为3.1 ± 1.0 和10.3 ± 2.0 μM。因此,这两个化合物在没有细胞毒性反应的情况下,显示了对癌症的化学预防潜力。
中国丝状真菌次级代谢分子调
2019-04-18
遗传, 2018, 40(10): 874-887 doi: 10.16288/j.yczz.18-169 综述 中国丝状真菌次级代谢分子调控研究进展 潘园园,1, 刘钢,1,2 1. 中国科学院微生物研究所,真...
Self-Fueled Biomimetic Liquid Metal M
2015-03-27
Self-Fueled Biomimetic Liquid Metal Mollusk Authors Jie Zhang, Youyou Yao, Lei Sheng, Jing Liu Abstract A liquid metal motor that can eat aluminum food and then move spontaneously a...
A New Golden Age of Natural Products
2016-07-23
Ben Shen DOI: http://dx.doi.org/10.1016/j.cell.2015.11.031 The 2015 Nobel Prize in Physiology or Medicine has been awarded to William C. Campbell, Satoshi Omura, and Youyou Tu for t...
“Click” reactions in polysacchari
2015-11-13
Xiangtao Meng a , b , Kevin J. Edgar a , b , , a Macromolecules and Interfaces Institute, Virginia Tech, Blacksburg, VA 24061, United States b Department of Sustainable Biomaterials...